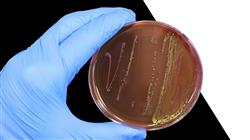

Qualificação universitária
A maior faculdade de enfermagem do mundo”
Apresentação do programa
Com este Curso, baseado na metodologia Relearning, você utilizará a Inteligência Artificial para identificar rapidamente os agentes patogênicos e seus perfis de resistência”

Um relatório recente das Nações Unidas prevê que as infecções resistentes a antimicrobianos custarão à economia global até US$ 100 trilhões nos próximos anos. Diante desse cenário, a Inteligência Artificial surge como uma ferramenta poderosa para enfrentar desafios como a resistência antimicrobiana e a rápida disseminação de patógenos emergentes. Nesse sentido, os profissionais de enfermagem têm um papel fundamental a desempenhar na adoção e aplicação dessas tecnologias. Portanto, esses profissionais precisam ter um conhecimento abrangente sobre o uso dessas ferramentas para melhorar a abordagem de tratamento de tais ferramentas, a fim de melhorar a abordagem das patologias infecciosas.
Nesse contexto, a TECH lança um revolucionário Curso de Inteligência Artificial em Microbiologia Clínica e Doenças Infecciosas para Enfermagem.O itinerário acadêmico se aprofundará em temas das áreas emergentes inter-relacionadas com essa tecnologia, incluindo ciência de dados e Big Data. Nesse sentido, a agenda se concentrará em como as ferramentas de aprendizado de máquina podem ser usadas para otimizar a vigilância epidemiológica e desenvolver terapias antimicrobianas que melhorem a qualidade de vida dos pacientes. Em especial, o programa incluirá um tópico inovador sobre o futuro da Inteligência Artificial em Microbiologia. A metodologia deste programa reforça seu caráter inovador.
A TECH oferece um ambiente educacional 100% online, adaptado às necessidades de enfermeiros que dispõem de pouco tempo e que buscam avançar em suas carreiras. Ele também emprega a metodologia Relearning, baseada na repetição de conceitos-chave para fixar o conhecimento e facilitar o aprendizado. Dessa forma, a combinação de flexibilidade e uma abordagem pedagógica robusta o torna altamente acessível. Além disso, os profissionais terão acesso a uma biblioteca rica em recursos multimídia em diferentes formatos audiovisuais (como resumos interativos, vídeos explicativos e infográficos).
Esta capacitação permitirá que você aprenda de maneira fluente, consistente e eficaz, proporcionando um salto de qualidade em sua carreira como profissional de enfermagem”
Este Curso de Inteligência Artificial em Microbiologia Clínica e Doenças Infecciosas para Enfermagem conta com o conteúdo científico mais completo e atualizado do mercado. Suas principais características são:
- Desenvolvimento de casos práticos apresentados por especialistas em Medicina, Parasitología e Microbiologia.
- O conteúdo gráfico, esquemático e eminentemente prático oferece informações científicas e práticas sobre as disciplinas que são essenciais para a prática profissional
- Contém exercícios práticos em que o processo de auto-avaliação é realizado para melhorar o aprendizado
- Destaque especial para as metodologias inovadoras
- Aulas teóricas, perguntas a especialistas, fóruns de discussão sobre temas controversos e trabalhos de reflexão individual
- Disponibilidade de acesso a todo o conteúdo a partir de qualquer dispositivo, fixo ou portátil, com conexão à Internet
Você aprenderá em profundidade as técnicas mais inovadoras de aprendizado automatizado para a identificação de bactérias”
O corpo docente deste curso inclui profissionais da área que transferem a experiência do seu trabalho para esta capacitação, além de especialistas reconhecidos de sociedades científicas de referência e universidades de prestígio.
O conteúdo multimídia, desenvolvido com a mais recente tecnologia educacional, permitirá ao profissional uma aprendizagem contextualizada, ou seja, realizada através de um ambiente simulado, proporcionando uma capacitação imersiva e programada para praticar diante de situações reais.
A estrutura deste programa se concentra na Aprendizagem Baseada em Problemas, através da qual o profissional deverá resolver as diferentes situações de prática profissional que surgirem ao longo do curso acadêmico. Para isso, contará com a ajuda de um inovador sistema de vídeo interativo realizado por especialistas reconhecidos.
Você aprenderá em detalhes sobre as técnicas mais inovadoras de aprendizado automatizado para a identificação de bactérias” Alcance esse objetivo com este programa”
Este Curso é 100% online e você poderá adaptá-lo às suas necessidades, o que facilita a sua realização durante suas práticas profissionais em tempo integral”
Porquê estudar no TECH?
A TECH é a maior universidade digital do mundo. Com um impressionante catálogo de mais de 14.000 programas universitários, disponíveis em 11 línguas, posiciona-se como líder em empregabilidade, com uma taxa de colocação profissional de 99%. Além disso, possui um enorme corpo docente de mais de 6.000 professores de renome internacional.
Estuda na maior universidade digital do mundo e garante o teu sucesso profissional. O futuro começa na TECH”
A melhor universidade online do mundo segundo a FORBES
A prestigiada revista Forbes, especializada em negócios e finanças, destacou a TECH como «a melhor universidade online do mundo». Foi o que afirmaram recentemente num artigo da sua edição digital, no qual fazem eco da história de sucesso desta instituição, «graças à oferta académica que proporciona, à seleção do seu corpo docente e a um método de aprendizagem inovador destinado a formar os profissionais do futuro».
Um método de estudo inovador, um corpo docente de vanguarda e a sua orientação prática: a chave do sucesso da TECH.
Os planos de estudos mais completos do panorama universitário
A TECH oferece os planos de estudos mais completos do panorama universitário, com programas que abrangem os conceitos fundamentais e, ao mesmo tempo, os principais avanços científicos nas suas áreas científicas específicas. Além disso, estes programas são continuamente atualizados para garantir aos estudantes a vanguarda académica e as competências profissionais mais procuradas. Desta forma, os cursos da universidade proporcionam aos seus alunos uma vantagem significativa para impulsionar as suas carreiras com sucesso.
A TECH possui os planos de estudos mais completos e intensivos do panorama universitário atual.
O melhor corpo docente top internacional
O corpo docente da TECH é composto por mais de 6.000 professores de renome internacional. Professores, investigadores e quadros superiores de multinacionais, incluindo Isaiah Covington, treinador de desempenho dos Boston Celtics; Magda Romanska, investigadora principal do Harvard MetaLAB; Ignacio Wistumba, presidente do departamento de patologia molecular translacional do MD Anderson Cancer Center; e D.W. Pine, diretor criativo da revista TIME, entre outros.
Especialistas de renome internacional, especializados em vários ramos da Saúde, Tecnologia, Comunicação e Negócios, fazem parte do corpo docente da TECH.
Um método de aprendizagem único
Um método de aprendizagem único A ##UNIVERS IDAD_SIGLAS## é a primeira universidade a utilizar o Relearning em todos os seus cursos. É a melhor metodologia de aprendizagem online, acreditada com certificações internacionais de qualidade de ensino, fornecidas por agências educacionais de prestígio. Além disso, este modelo académico disruptivo é complementado pelo “Método do Caso”, configurando assim uma estratégia única de ensino online. São também implementados recursos didácticos inovadores, incluindo vídeos detalhados, infografias e resumos interativos.
A TECH combina o Relearning e o Método do Caso em todos os seus programas universitários para garantir uma excelente aprendizagem teórica e prática, estudando quando e onde quiser.
A maior universidade digital do mundo
A TECH é a maior universidade digital do mundo. Somos a maior instituição educativa, com o melhor e mais extenso catálogo educativo digital, cem por cento online abrangendo a grande maioria das áreas do conhecimento. Oferecemos o maior número de títulos próprios, pós-graduações e licenciaturas oficiais do mundo. No total, são mais de 14.000 títulos universitários, em onze línguas diferentes, o que nos torna a maior instituição de ensino do mundo.
A TECH conta com o mais extenso catálogo de programas académicos e oficiais do mundo e está disponível em mais de 11 línguas.
Google Partner Premier
O gigante tecnológico americano atribuiu à TECH o distintivo Google Partner Premier. Este prémio, que só está disponível para 3% das empresas no mundo, destaca a experiência eficaz, flexível e adaptada que esta universidade proporciona aos estudantes. O reconhecimento não só acredita o máximo rigor, desempenho e investimento nas infra-estruturas digitais da TECH, mas também coloca esta universidade como uma das empresas de tecnologia mais avançadas do mundo.
A Google colocou a TECH no top 3% das empresas tecnológicas mais importantes do mundo, atribuindo-lhe o distintivo Google Partner Premier.
A universidade online oficial da NBA
A TECH é a Universidade Online Oficial da NBA. Através de um acordo com a maior liga de basquetebol, oferece aos seus estudantes programas universitários exclusivos, bem como uma grande variedade de recursos educativos centrados no negócio da liga e noutras áreas da indústria desportiva. Cada programa tem um plano de estudos único e conta com oradores convidados excepcionais: profissionais com um passado desportivo distinto que oferecem os seus conhecimentos sobre os temas mais relevantes.
A TECH foi reconhecida pela NBA, a liga de basquetebol mais importante do mundo, como a sua universidade online oficial.
A universidade mais bem classificada pelos seus alunos
A Global score posicionou a TECH como a universidade mais bem avaliada do mundo pelos seus estudantes. Este portal de avaliação, o mais fiável e prestigiado porque verifica e valida a autenticidade de cada opinião publicada, atribuiu à TECH a sua classificação mais elevada, 4,9 em 5, com base em mais de 1000 avaliações recebidas. Estes números colocam a TECH como a referência universitária internacional absoluta. Estes resultados consolidam a TECH como uma instituição universitária de referência internacional, refletindo a excelência e o impacto positivo do seu modelo educativo”
A TECH é a universidade mais bem classificada pelos seus alunos no mundo.
Líderes em empregabilidade
A TECH conseguiu tornar-se a universidade líder em empregabilidade. 99% dos seus estudantes conseguem um emprego na área académica que estudaram, no prazo de um ano após a conclusão de qualquer um dos programas da universidade. Um número semelhante consegue uma melhoria imediata da sua carreira. Tudo isto graças a uma metodologia de estudo que baseia a sua eficácia na aquisição de competências práticas, absolutamente necessárias para o desenvolvimento profissional.